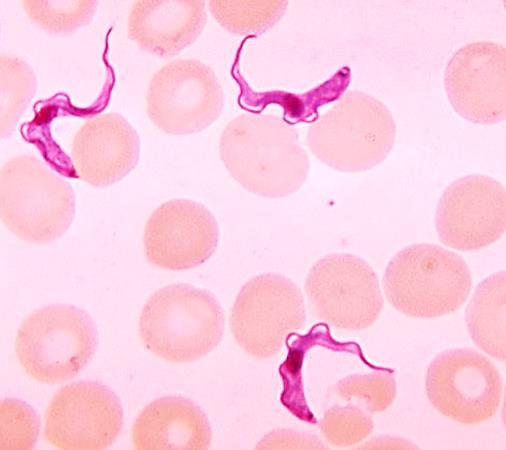

Hvmani Corporis Educacional Patologia Geral



![]()








Conceitos fundamentais

Infecção:
Fenômeno caracterizado pela invasão e colonização do organismo por um agente biológico, que pode resultar em danos teciduais e prejuízos funcionais (doença) de gravidade variável.
Agente infeccioso:
Organismo (uni ou multicelular) que protagoniza a infecção, cuja presença é necessária (mas não suficiente) para que se desenvolva eventual doença.
Hospedeiro:
Organismo que proporciona alojamento e subsistência a um agente infeccioso, tornando-se deste um potencial transmissor, que pode ou não evoluir com doença.



Conceitos fundamentais

Reservatório:
Habitat natural, lugar em que tipicamente vive, cresce e se multiplica um agente infeccioso, que pode consistir em um ambiente não biológico (em geral o solo ou água) ou biológico (outro organismo, inclusive o humano).
Transmissão:
Transferência de um agente infeccioso do seu hospedeiro prévio ou reservatório para um hospedeiro susceptível, por meios diretos ou indiretos.
Contaminação:
Designa a simples presença de um agente potencialmente infeccioso, vivo, sobre a superfície corporal, vestes ou outros objetos inanimados ou substâncias quaisquer (água, alimentos).








Entre 1865 e 1890, Louis Pasteur, Robert Koch e Joseph Lister implicaram microrganismos como agentes causais de doenças, trazendo uma revolução à ciência médica.


Frequência e distribuição das doenças infecciosas
Considerações gerais:
- importante causa de morbimortalidade no mundo (terceira causa de mortes);
- pode haver significativa variação na incidência e gravidade/letalidade conforme a idade, estado nutricional, condição social, geografia, hábitos e comorbidades.



Prevalência histórica das doenças infecciosas no mundo (vermelho: maior prevalência).





Incidência das doenças infecciosas no Brasil entre 2010 e 2017, conforme o Ministério da Saúde (vermelho: maior incidência).


Frequência e distribuição das doenças infecciosas
Considerações gerais:
- as infecções respiratórias agudas (principalmente virais, de vias superiores), gastroentéricas (diversos agentes) e hepáticas (virais) são as mais frequentes; - infecções pulmonares (pneumococo, micobactéria), síndromes diarreicas e HIV/AIDS são as causas de morte mais comuns.


Principais causas de mortalidade por infecção no mundo, em 2019 (ourworldindata.org).


Considerações gerais:
- população mais numerosa (~ 40 trilhões) do que as células próprias do corpo, com que mantêm relação simbiótica de comensalismo ou mutualismo;
- sua composição têm início ao nascimento (ou antes) e se estabiliza até o terceiro ano de vida (mas sujeita a modificações posteriores e variações individuais).




O nascimento via vaginal oportuniza o contato com uma ampla variedade de microrganismos que integrarão a microbiota normal, em colaboração com diversas outras experiências posteriores (como contato interpessoal e alimentação).



Considerações gerais:
- sua presença dificulta a instalação e proliferação de agentes tipicamente patogênicos (antagonismo microbiano);
- a relação positiva com a microbiota não é incondicional (competência imunológica e topografia são fatores); a maioria das doenças, ainda assim, é causada por não indígenas.




Considerações gerais:
- sua distribuição e composição dependem de fatores nutricionais (disponibilidade de alimento), químicos (p. ex., pH, O2), físicos (p. ex., temperatura) e imunológicos;
- diferentes comunidades podem ser encontradas especialmente na superfície epidérmica e conjuntival, vias aéreas superiores, boca, intestinos (maior variedade e quantidade), uretra distal (1 cm) e vagina.




Considerações gerais:
- bactérias (múltiplos gêneros) constituem os principais representantes, mas vírus, fungos e protozoários também podem ser encontrados; - a compreensão do papel da microbiota na saúde e doença ainda requer avanços.







Considerações gerais:
- a infecção de um hospedeiro em potencial é o produto final de uma sequência organizada e cíclica de eventos;
- o conhecimento dos elos da cadeia é essencial para a formulação de medidas preventivas/terapêuticas eficazes contra as doenças infecciosas.


Hospedeiros susceptíveis
Rotas de entrada
Modos de transmissão

Agentes infeciosos
Elementos básicos da cadeia infecciosa.


Agentes infecciosos:
- de natureza muito diversa, incluem vírus, bactérias, fungos, protozoários e metazoários; - as formas de aquisição/transmissão e o perfil dos hospedeiros podem variar amplamente conforme o agente considerado; - a infectividade, a patogenicidade e a virulência podem ser muito distintas entre diferentes agentes.






Além dos vírus, organismos uni e multicelulares, micro ou macroscópicos, podem atuar como agentes da infecção em humanos.



Agentes infecciosos:
- infectividade: capacidade do agente de alojar-se em um hospedeiro e colonizá-lo (quanto maior a proporção de infectados após exposição ao agente ou menor a dose infectante, maior sua infectividade);
- patogenicidade: capacidade que tem o agente de gerar doença no hospedeiro (quanto maior a proporção, entre os infectados por um agente, daqueles que desenvolvem doença, maior sua patogenicidade);
- virulência: capacidade do agente infeccioso de produzir doença grave, com potencial de letalidade.







O vírus do sarampo exibe altíssima infectividade (podendo chegar a 100%) e alta patogenicidade, mas baixa virulência.






O vírus ebola exibe altíssima virulência (com até 90% de letalidade), mas baixa infectividade.






A Yersinia pestis, causadora da peste, exibe altas infectividade e virulência, matando em poucos dias 70% dos doentes.



Fonte da infecção:
- diz-se do local de onde proveio o agente que infectou um indivíduo; - pode consistir no próprio reservatório do agente, num hospedeiro qualquer (inclusive o infectado que não manifesta doença ou portador) ou objeto/substância contaminado; - infecções por agentes provenientes de animais não humanos configuram as zoonoses (p.ex.,vírus da raiva, Campylobacter spp., Salmonella spp., Leptospira spp., Yersinia spp., Toxoplasma gondii, Taenia spp.).



Os humanos são comuns fontes de agentes infecciosos.


Fonte da infecção






Animais silvestres e domésticos, o solo, água e alimentos são possíveis fontes de infecções.


Rotas de saída do organismo:
- quando a fonte tratar-se de um hospedeiro (humano ou não), compreendem os caminhos pelos quais o agente deixa seu corpo e se torna disponível para a transmissão; - em geral relacionadas aos sítios em que o agente se aloja, incluem as vias aérea (nariz, boca), digestória (boca, ânus), urogenital (uretra, vagina), lactífera (mamas) e placentária; - a descontinuidade traumática (p.ex., picadas, mordeduras, perfurações, incisões) ou patológica (p.ex., ulcerações, vesículas rotas) da pele/mucosas proporciona rota de saída para agentes presentes nestas topografias (ou no sangue).




Modos de transmissão:
- um agente pode ser transportado direta ou indiretamente do seu reservatório/hospedeiro prévio até um hospedeiro em potencial; - a transmissão direta implica o contato não intermediado (por elementos externos) com o reservatório/hospedeiro (seus fluidos corporais [saliva, muco, lágrima, leite, esperma, urina, vômito, sangue, exsudatos] ou dejetos, conforme o agente).




O contado direto entre pessoas consiste num importante modo de transmissão de agentes infecciosos.



Modos de transmissão




A transmissão "vertical" se dá diretamente da mãe para o filho durante a gestação (p.ex., HIV, vírus da rubéola, Treponema pallidum, T. gondii), parto (p.ex., HIV, Neisseria gonorrhoeae, Chlamydia spp.) ou aleitamento (p.ex., HIV, HBV).



Modos de transmissão:
- a emissão de gotículas (>100 μm) e aerossóis (≤100 μm) de muco, saliva e/ou exsudato contendo agentes infecciosos constitui a principal forma de transmissão (direta ou indireta) das infecções respiratórias; - gotículas exibem comportamento balístico e alcance em torno de 1m, enquanto aerossóis podem permanecer suspensos no ar por várias horas e ser carregados por longas distâncias.



Atos expiratórios (expirar, falar, tossir, espirrar) emitem gotículas e aerossóis no ambiente. Tossir gera a emissão de aprox. 3 mil gotículas pela boca/nariz, e espirrar, 40 mil. A quantidade de aerossóis em cada caso é ainda maior.



Modos de transmissão



Indivíduo infectado

Ácinos
Brônquios
Hospedeiro em potencial
Aerossóis (flutuação)
Gotículas (trajetória balística)
Superfície contaminada (Alcance)
A trajetória e alcance de gotículas e aerossóis dependem de múltiplos fatores, como tamanho, velocidade de emissão e condições ambientais (temperatura, umidade, correntes de ar).


Modos de transmissão:
- a transmissão indireta implica a intermediação por elementos externos inanimados (veículos) ou animados (vetores);
- veículos incluem substâncias (água, ar, alimentos) ou objetos contaminados (fômites: vestes, lenços, roupas de cama, brinquedos, copos, talheres, instrumentos médicos, assentos, corrimãos);
- o tempo durante o qual um agente permanece viável em um veículo pode variar muito conforme sua natureza e condições ambientais (p.ex., temperatura, radiação solar).




Modos de transmissão



A exposição à água contaminada representa sério problema de saúde pública em diversas localidades no mundo.



Modos de transmissão



O consumo de alimentos contaminados leva ao adoecimento de centenas de milhões de pessoas todos os anos.



Modos de transmissão



Profissionais da saúde estão sob constante risco de infecção intermediada por objetos contaminados.



Modos de transmissão:
- vetores são mediadores vivos (tipicamente, artrópodes) que transportam o agente infeccioso até um potencial hospedeiro, seu alimento ou seu ambiente imediato;
- um vetor pode desempenhar papel puramente mecânico (similar ao de um veículo) ou sediar algum desenvolvimento do agente.




Modos de transmissão






Mosquitos (Aedes aegypti, Anopheles spp., Lutzomyia spp.) e carrapatos (Ixodes spp.), além de moscas e baratas domésticas, são exemplos de vetores para agentes que infectam humanos.


Rotas de entrada no organismo:
- caminhos pelos quais o agente infeccioso invade o corpo do hospedeiro e obtém acesso aos sítios/tecidos onde se instala e se multiplica;
- podem ou não coincidir com as rotas de saída do mesmo agente;
- incluem as vias aérea (inalação), digestória (ingestão), urogenital (ascensão ou inoculação sexual) e transcutânea/mucosa (invasão por descontinuidade traumática ou patológica da superfície epitelial).



Cerca de 90% das infecções que um indivíduo contrai ao longo da vida têm as vias aéreas como rota de entrada.


Rotas de entrada no organismo



Traumatismos cutâneos/mucosos criam rotas de entrada para agentes infecciosos (à direita, orifício cutâneo de punção por agulha observado à microscopia eletrônica de varredura).



Rotas de entrada no organismo



Traumatismos cutâneos impostos por mordedura ou picada de animais proporcionam rota de entrada para agentes diversos, inclusive os eventualmente transmitidos pelo efetor do trauma.



Rotas de entrada no organismo



As cercárias do Schistosoma spp. invadem o corpo através da pele ou mucosas mesmo quando íntegras, mediante a produção de moléculas que promovem acantólise, necrose e apoptose do epitélio (setas: túnel epidérmico).



Rotas de entrada no organismo:
- as potenciais rotas de entrada são naturalmente equipadas por mecanismos de defesa que visam impedir infecções;
- barreiras físicas (epitélios, pelos orificiais, esfíncteres, muco) e químicas (acidez, enzimas líticas/digestivas, ác. graxos livres, toxinas antimicrobianas), atividade ciliar, macrofagócitos superficiais e a microbiota indígena representam defesas primárias contra agentes invasores.



O bom funcionamento da esteira mucociliar do epitélio respiratório é essencial para a defesa das vias aéreas.



Rotas de entrada no organismo



Macrofagócitos alveolares

Macrofagócitos residentes nas superfícies alveolares estão sempre "atentos" à presença de invasores.


Rotas de entrada no organismo:
- a presença de IgA em fluidos como saliva, muco, suor e urina impõe obstáculo adicional à invasão por agentes infecciosos;
- mecanismos adjuvantes incluem os reflexos da tosse/espirro e vômito, a peristalse intestinal (mobilização/eliminação de eventuais invasores, controle dos comensais) e a micção (acidez).




Hospedeiros susceptíveis:
- quaisquer indivíduos que exibam algum favorecimento à infecção por um determinado agente;
- fatores biológicos, ambientais, socioeconômicos e culturais influenciam a susceptibilidade à infecção/doença;
- imunidade inata e/ou adquirida prejudicada ou insuficiente, desnutrição, obesidade, sedentarismo, tabagismo, etilismo, ausência de vacinação, comorbidades e extremos de idade tipicamente favorecem a infecção (e com maior gravidade);
- após infectados, tornam-se potenciais fontes de infecção.




Hospedeiros susceptíveis:
- período de transmissão: intervalo de tempo durante o qual um hospedeiro (humano ou não) pode atuar como fonte de um agente infeccioso (isto é, transmiti-lo a outros indivíduos);
- período de latência: intervalo de tempo entre a instalação da infecção e o início do período de transmissão;
- período de incubação: intervalo entre a instalação da infecção e o surgimento (quando for o caso) de sinais/sintomas de doença (durante o qual, em geral, já pode haver transmissão).


Portadores, por desconhecerem sua condição, são comuns fontes de infecção. Os doentes tendem a circular menos (debilidade) e a receber tratamentos específicos, além de adotar medidas preventivas, o que limita a dispersão do agente.


Hospedeiros susceptíveis:
- o comprometimento de uma proporção significativa de indivíduos susceptíveis pode caracterizar-se como:
-- surto: aumento localizado do número de casos de uma doença infecciosa (p. ex., em um hospital ou escola);
-- epidemia: aumento de casos não limitado a um local específico, podendo a abrangência ser regional, municipal, estadual ou nacional;
-- pandemia: quando a abrangência é internacional ou intercontinental;
-- endemia: quando a presença de uma doença infecciosa (logo, do seu agente) é habitual em uma determinada região.



Possíveis expressões de uma doença infecciosa.


Multiplicação e disseminação do agente:
- suplantados os mecanismos defensivos primários em sua rota de entrada, o agente infeccioso passa a colonizar o organismo hospedeiro, multiplicando-se no espaço extracelular ou no interior das células (a depender do agente específico);
- enquanto a maioria dos agentes permanece restrita ao sítio primário da infecção (conforme a rota de entrada), alguns podem disseminar-se para tecidos/órgãos distantes.




Multiplicação e disseminação do agente:
- a fixação/adesão do agente aos tecidos do hospedeiro é tipicamente mediada por moléculas adesivas ou adesinas (cuja ausência natural de um ligante específico no hospedeiro pode torná-lo imune à infecção);
- alguns agentes aderem aos epitélios e os colonizam superficialmente (p.ex., Vibrio cholerae, alguns subtipos de Escherichia coli, Giardia lamblia), enquanto outros podem penetrá-los, sem extrapolá-los (p.ex., fungos dermatófitos);
- a capacidade de transpor epitélios e invadir outros tecidos exibida por alguns agentes (p.ex., Campylobacter spp., Salmonella spp., Entamoeba histolitica) é favorecida pela secreção de toxinas e enzimas degradantes.




Multiplicação e disseminação do agente: - a circulação sanguínea pode ser alcançada a partir de invasão direta ou pela drenagem linfática de agentes livres ou capturados por células sentinela, que acabam por escapar da resposta imune nos linfonodos; - o sangue é a mais comum (e eficiente) via de disseminação de um agente, seja livremente no plasma (maioria das bactérias e fungos) ou utilizando leucócitos (p.ex., HIV) ou hemácias (p.ex., Plasmodium spp.) como veículo.




Esfregaço de sangue periférico acusando a presença de bactérias bacilares (à esquerda; setas) e protozoários intra-eritrocitários (Plasmodium falciparum, à direita).


Multiplicação e disseminação do agente



A conquista da circulação por agentes (em especial) de alta virulência constitui cenário grave, com elevado potencial de letalidade.


Multiplicação e disseminação do agente: - o tropismo por fibras nervosas exibido por alguns vírus (p.ex., poliovírus, vírus da varicela, vírus da raiva) permite que estas sejam utilizadas como vias de propagação no hospedeiro.


Infecção por via nervosa (descendente) de outros órgãos

Infecção do encéfalo
Inoculação do vírus
Ascenção pela medula espinal
Ascenção à raiz dorsal
Replicação intramuscular e entrada pela placa motora
Disseminação via nervosa do vírus da raiva.


Respostas do organismo à infecção
Reações inatas:
- embora pouco específicas, proporcionam pronta atuação contra agentes infecciosos, constituindo importante fator limitador da patogenicidade para muitos deles;
- além da inflamação, incluem a atividade de macrofagócitos locais, células NK (citotoxicidade), complemento (citólise, opsonização) e interferons tipo 1 (IFN-α, β, ω) sintetizados pelas células infectadas e sentinelas (bloqueio da replicação viral).




Respostas do organismo à infecção
Reações inatas:
- a inflamação pode ser diretamente acionada pelo reconhecimento (células sentinela) de centenas de padrões moleculares diferentes; - diversos constituintes da superfície de um agente, além de enzimas e produtos do seu metabolismo, podem ser prontamente reconhecidos.




Respostas do organismo à infecção
Reações específicas:
- uma resposta imune específica (conforme o agente) assegura a defesa contra organismos capazes de burlar ou resistir à reação inflamatória e demais mecanismos inatos; - os mecanismos da imunidade específica variam conforme a situação (intra ou extracelular) do agente e sua natureza biológica.




Respostas do organismo à infecção
Reações específicas:
- contra vírus: incluem a atuação de linfócitos T citotóxicos sobre células infectadas (expressão de antígenos virais pelo MHC I) e de anticorpos (vírus em situação extracelular) que se ligam ao envelope viral, impedindo sua entrada nas células-alvo ou atuando como opsoninas;
- contra bactérias/fungos intracelulares: incluem a atuação de linfócitos
T citotóxicos e de macrofagócitos estimulados (IFN-γ) por linfócitos TH1 ativados pela IL-12 (dendrócitos, macrofagócitos).




Respostas do organismo à infecção
Reações específicas:
- contra bactérias/fungos extracelulares: incluem a ação de anticorpos produzidos por linfócitos B ativados direta (antígenos não proteicos) ou indiretamente (antígenos proteicos, via interação com linfócito T cognato) e o recrutamento de fagócitos inflamatórios induzido (IL-17) por linfócitos TH17 ativados pela IL-23 (dendrócitos, macrofagócitos);
- contra proto/metazoários: protozoários intracelulares são combatidos por mecanismos semelhantes aos aplicados contra bactérias e fungos intracelulares; contra helmintos, incluem a ação de anticorpos IgE e fagócitos inflamatórios, em particular eosinófilos, induzidos (IL-4, IL-5) por linfócitos TH2 ativados pela IL-4 (macrofagócitos).




Respostas do organismo à infecção
Insuficiência imunológica:
- debilidades congênitas ou adquiridas em um ou mais mecanismos da imunidade podem sujeitar o indivíduo a infecções mais frequentes e/ou graves, inclusive por agentes tipicamente inócuos (oportunistas);
- condições congênitas incluem defeitos do complemento, adesão leucocitária, fagolisossomas e maturação/ativação de linfócitos (B e T);
- condições adquiridas incluem desnutrição, AIDS, neoplasias, distúrbios da hematopoese e terapias imunossupressoras.




O fungo Pneumocystis jirovecii (à direita), raramente patogênico em imunocompetentes, é um importante agente de infecções pulmonares em imunodeprimidos.


Considerações gerais:
- a sobrevivência de um agente em seu hospedeiro depende da sua capacidade de evadir-se, resistir ou prejudicar a resposta imunológica; - as estratégias exibidas por um agente infeccioso para burlar as defesas do organismo agregam-lhe infectividade, patogenicidade e virulência.



O incessante embate entre agentes infecciosos e a imunidade de seus hospedeiros tem alimentado sua coevolução ao longo do tempo.


Principais estratégias:
- dos vírus: variações na expressão de antígenos de superfície, inibição da síntese de interferons tipo 1, síntese de fatores que interferem na atuação de citocinas, síntese de bloqueadores do complemento, interferência na apresentação de antígenos (pelo MHC I);
- das bactérias intracelulares: escape dos fagossomas, inibição da formação dos fagolisossomas e inativação de degradantes (como radicais livres).




Principais estratégias:
- das bactérias extracelulares: variações de antígenos de superfície, síntese de cápsulas polissacarídicas (reconhecimento/fagocitose), inibidores da quimiotaxia de leucócitos, bloqueadores do complemento e fatores líticos (leucocidinas) que destroem fagócitos;
- dos fungos: inibição da síntese de citocinas pró-inflamatórias e estímulo à síntese de anti-inflamatórias (mecanismos em geral pouco conhecidos);
- dos proto/metazoários: variações de antígenos de superfície (inclusive estágio específicas), cistificação, inibição da resposta imune (mecanismos pouco compreendidos).




Mecanismos patogênicos
Considerações gerais:
- as respostas imunológicas do organismo podem não ser bem sucedidas em erradicar otimamente (em caráter subclínico) um agente infeccioso, favorecendo a doença; - a ocorrência de doença (e sua gravidade) depende de fatores do agente e do hospedeiro (competência imunológica, comorbidades, acesso à assistência médica).




Considerações gerais:
- a doença infecciosa em geral resulta da atuação (1) direta local do agente ou (2) indireta, mediada por toxinas, ou, ainda (3), de efeitos adversos da resposta imunoinflamatória;
- no interior das células, a atividade metabólica mobilizada pelo agente e a sua replicação são comuns causas de disfunção, lesão e/ou morte celular (por necrose ou apoptose).




Mecanismos patogênicos da infecção
Considerações gerais:
- toxinas podem agir localmente (mais comum) ou à distância (via circulação), extra ou intracelularmente ou danificando a membrana celular, mediante proteólise, lipólise ou indução de poros, dentre outros;
- exotoxinas têm natureza proteica e são secretadas, enquanto endotoxinas constituem porções lipopolissacarídicas da parede celular de bactérias
"Gram-negativas" (E. coli, Proteus spp., Enterobacter spp., Serratia spp., Klebsiella spp., Pseudomonas aeruginosa), liberadas mediante sua quebra.




Mecanismos patogênicos
Considerações gerais:
- a resposta imunoinflamatória pode eventualmente tornar-se mais danosa que a própria infecção (choque, inflamação crônica, autoimunidade);
- a não erradicação do agente leva, quando não à morte do indivíduo, à cronificação da doença ou à condição de portador;
- algumas infecções (p. ex., HPV, EBV) impõem às células alterações moleculares capazes de transformá-las neoplasicamente (potencial oncogênico).




Possíveis caminhos evolutivos:
- resolução em caráter subclínico (sem doença manifesta);
- resolução após período de doença;
- doença persistente ou morte do hospedeiro;
- doença recorrente (intercalam-se períodos de latência e atividade).



Imunidade inata Imunidade adquirida
Morte ou doença crônica persistente
Período de incubação
Doença
Doença crônica recorrente
Evolução subclínica (assintomática)
Resolução ótima
Resolução da doença (cura)
A imunidade pode ou não ser bem sucedida no controle das doenças infeciosas.


Considerações gerais:
- parasitas intracelulares obrigatórios, constituídos por uma molécula de DNA ou RNA alojada numa cápsula proteica;
- menores agentes infecciosos conhecidos (20-300 ηm de diâmetro);
- classificados em mais de 120 famílias (-viridae), 730 gêneros (-virus) e 4400 espécies, conforme sua morfologia, genoma e estratégias de replicação;
- diversas integram a microbiota normal.







O adenovírus (à esquerda; da família Adenoviridae), o HIV (centro; da família Retroviridae) e o vírus da raiva (à direita; da família Rabdoviridae) exibem formas completamente distintas (imagens de micrografia eletrônica de transmissão).



Considerações gerais:
- viroses envolvendo vias aéreas superiores e/ou trato gastrintestinal são as mais comuns;
- as "arboviroses" são transmitidas por artrópodes (Aedes aegypti: dengue, Zika, Chikungunya e febre amarela urbana; Haemagogus spp. e Sabethes spp.: febre amarela silvestre);
- o diagnóstico do agente viral (quando necessário) requer pesquisa de anticorpos (testes sorológicos) ou do DNA/RNA viral (PCR).




Principais agentes de interesse:
- vírus de DNA: Adenoviridae (adenovírus), Hepadnaviridae (HBV), Herpesviridae (vírus do herpes simples, vírus da varicela-zoster, CMV, EBV), Papillomaviridae (HPV), Poxviridae (vírus da varíola).
- vírus de RNA: Caliciviridae (norovírus), Coronaviridae (SARS-CoV-2), Flaviviridae (vírus da dengue, vírus da febre amarela, Zika vírus, HCV),
Orthomyxoviridae (vírus da influenza), Picornaviridae (enterovirus [poliovírus, rinovírus], hepatovirus [HAV]), Paramyxoviridae (vírus do sarampo, vírus da caxumba), Togaviridae (vírus da rubéola, CHIKV), Reoviridae (rotavírus), Retroviridae (HIV), Rhabdoviridae (vírus da raiva).




Principais agentes de interesse:



Da família Coronaviridae, o SARS-CoV-2, causador da COVID-19, em imagem de microscopia eletrônica de transmissão colorizada.


Particularidades da interação com o hospedeiro:
- todos os vírus necessitam ligar-se às células do hospedeiro e penetrá-las, a fim de replicar-se no seu interior (utilizando o maquinário e metabolismo celular);
- a infecção pelos vírus em geral mata as células hospedeiras.




Particularidades da interação com o hospedeiro:
- a replicação viral interfere na síntese proteica da célula, além de gerar proteínas virais que podem lhe ser tóxicas ou enzimas com ação degradante;
- a atividade viral interfere no funcionamento da célula como um todo, favorecendo lesão e morte celular (por necrose ou apoptose) ou transformação maligna (EBV, HPV).




Particularidades da interação com o hospedeiro: - as alterações citomorfológicas da infecção viral designam-se efeitos citopáticos (cito/cariomegalia, multinucleação, inclusões nucleares e citoplasmáticas) e servem como critérios diagnósticos.



Células do epitélio esofágico exibindo efeitos citopáticos da infecção pelo vírus do herpes simples (à direita, epitélio esofágico normal para comparação).



Infecções bacterianas
Considerações gerais:
- seres unicelulares procariontes, extra (maioria) ou intracelulares facultativos ou obrigatórios, medindo 0.1-10 μm;
- as formas básicas são arredondadas (cocos), alongadas (bacilos) ou helicoidais (espiroquetas), avulsas ou agrupadas; - quanto ao metabolismo energético, podem ser aeróbias, anaeróbias ou facultativas (maioria); - tradicionalmente classificadas conforme a coloração de Gram, por sua relevância clínica.




Considerações gerais:


Bactérias Gram + Bactérias Gram -
Pela técnica de Hans Gram, bactérias previamente coradas que mantêm uma tonalidade arroxeada mesmo após banhadas por um solvente identificam-se como "Gram-positivas", e as que se descoram, como "Gram-negativas".



Considerações gerais:

Parede celular
Membrana plasmática

Bactéria Gram +

Proteína membranar
Lipopolissacarídeo
Peptidoglicano
Ác. lipoteicoico
Parede celular
Membrana externa
Peptidoglicano
Membrana plasmática

Periplasma

Bactéria Gram -
Porina
Lipoproteína
Fosfolipídeo
Proteína transmembranar
As bactérias "Gram-positivas" exibem uma parede celular mais simples em comparação às "Gram-negativas", o que se associa a diferentes graus de virulência e lhes confere diferentes sensibilidades à antibioticoterapia.



Considerações gerais:
- o diagnóstico do agente bacteriano (quando necessário) pode ser feito por cultura ou pesquisa de anticorpos (testes sorológicos) ou do DNA bacteriano (PCR);
- em alguns casos, o exame cito/histopatológico (com colorações especiais) é suficiente para a identificação do agente.



Placa de cultura em ágar-sangue (à esquerda) e bacterioscopia (1000x) à coloração de Ziehl-Neelsen (à direita).



Considerações gerais:



Biópsia do antro gástrico exibindo múltiplos Helicobacter pylori junto ao epitélio, à coloração de Giemsa.



Principais agentes de interesse:
- "Gram-positivos": Clostridioides difficile, Clostridium botulinum,
Clostridium tetani, Corynebacterium diphtheriae, Enterococcus spp., Lactobacillus spp., Listeria monocytogenes, Mycobacterium leprae e Mycobacterium tuberculosis (fracamente), Staphylococcus aureus, Streptococcus pneumoniae (pneumococo), Streptococcus pyogenes.




Staphylococcus aureus (à esquerda), Streptococcus pyogenes (centro) e Lactobacillus spp. (à direita).



Principais agentes de interesse: - "Gram-negativos": Bacteroides spp., Bordetella pertussis, Campylobacter jejuni, Enterobacter spp., Escherichia coli, Haemophilus influenzae, Helicobacter pylori, Klebsiella spp., Leptospira spp. (fracamente), Moraxella catarrhalis, Neisseria gonorrhoeae, Neisseria meningitidis (meningococo), Pseudomonas aeruginosa, Proteus mirabilis, Rickettsia spp. (fracamente), Salmonella spp., Serratia spp., Shigella spp., Treponema pallidum (fracamente), Vibrio cholerae, Yersinia pestis.




Neisseria meningitidis (à esquerda), Leptospira interrogans (centro) e Helicobacter pylori (à direita).



Principais agentes de interesse: - atípicos (não coráveis pela técnica de Gram): Chlamydia pneumoniae, Chlamydia trachomatis, Mycoplasma pneumoniae, Ureaplasma parvum, Ureaplasma urealyticum.




Mycoplasma pneumoniae (à esquerda) e Ureaplasma parvum à microscopia eletrônica de varredura.


Particularidades da interação com o hospedeiro:
- a adesão bacteriana é favorecida por pelos e flagelos, que exibem aderência (adesinas) a moléculas da superfície celular ou da matriz extracelular (fibronectina, laminina, colágeno, fibrinogênio);
- algumas bactérias secretam invasinas, que reorganizam localmente o citoesqueleto da célula a ser invadida, facilitando sua penetração.




Infecções bacterianas
Particularidades da interação com o hospedeiro:
- enzimas bacterianas (colagenases, hialuronidases, coagulases, IgA proteases) colaboram com o processo de invasão e disseminação;
- a síntese de fatores antifagocitose ou antiquimiotáticos, de bloqueadores do complemento e fatores líticos (contra fagócitos) favorece a sobrevivência de diversos agentes bacterianos no ambiente extracelular;
- o escape de fagossomas, a inibição da formação de fagolisossomas e a neutralização de radicais livres favorece a sobrevivência de bactérias intracelulares.




Particularidades da interação com o hospedeiro:
- a produção de toxinas é o principal fator de virulência;
- exotoxinas são produzidas por "Gram-positivas" e "Gram-negativas", enquanto endotoxinas (lipopolissacarídeos da parede celular) são exclusivas das "Gram-negativas" e liberadas à ocasião da sua morte;
- mecanismos de ação e efeitos das toxinas variam (podendo ser letais);
- as endotoxinas são tipicamente pirogênicas e agregam virulência à infecção (rabdomiólise, coagulação intravascular disseminada, choque).




Particularidades da interação com o hospedeiro:

Toxina tetânica (paralisia espástica)

Toxina botulínica (paralisia flácida)

Algumas toxinas têm efeitos neurotóxicos, a exemplo das clássicas toxinas tetânica (do Clostridium tetani), a provocar paralisia espástica (à esquerda), e botulínica (do Clostridium botulinum), a provocar paralisia flácida (à direita).



Particularidades da interação com o hospedeiro:
- as infecções por anaeróbios em geral são polimicrobianas;
- tipicamente há contexto de trauma, cirurgia, isquemia e/ou necrose em associação às infecções anaeróbias;
- bactérias anaeróbias são tipicamente supurativas e abscedantes (com odor fétido característico), além de mais resistentes às terapias antibióticas convencionais.




Particularidades da interação com o hospedeiro: - nas infecções por micobactérias (aeróbios), um padrão morfológico granulomatoso de inflamação é característico.





Infecções fúngicas
Considerações gerais:
- seres uni ou pluricelulares eucariontes, extra ou intracelulares obrigatórios ou facultativos; - de importância infectológica, leveduras (células ou ocasionais cadeias celulares/pseufo-hifas) e bolores (filamentos multicelulares ou hifas), alguns sendo dimórficos (podem existir como levedura ou bolor, conforme as condições ambientais).




Infecções fúngicas
Considerações gerais:
- dezenas de espécies integram a microbiota normal (Candida spp., Aspergillus spp.);
- água, solo e outros animais são importantes reservatórios; - o diagnóstico pode ser cito/histológico (com colorações especiais), mas muitas vezes requer cultura; sorologias e pesquisa de DNA podem ser empregados conforme o caso;
- não há vacinas disponíveis.




Aspecto histopatológico da infecção do epitélio esofágico por Candida albicans (à esquerda) e da epiderme por Trichophyton spp. (à direita) à coloração PAS (periodic acid-Schiff).


Principais agentes de interesse:
- Candida albicans, Cryptococcus spp., Malassezia spp. e Pneumocystis jirovecii (leveduras), Aspergillus spp., Epidermophyton spp., Microsporum spp. e Tricophyton spp. (bolores), Histoplasma capsulatum, Blastomyces dermatitidis, Coccidioides spp. e Paracoccidioides spp. (dimórficos).






Principais agentes de interesse:



Esporos de Histoplasma capsulatum (à esquerda) e hifas de Coccidioides immitis (à direita).



Infecções fúngicas
Particularidades da interação com o hospedeiro:
- podem infectar desde a epiderme e/ou fâneros e mucosa
oral/vaginal até o subcutâneo e tecidos viscerais (esôfago, pulmões, SNC), com eventual alcance multissistêmico;
- doença visceral é mais frequente em imunocomprometidos;
- candidíase e dermatofitoses são as micoses mais comuns na população geral.




Infecções fúngicas
Particularidades da interação com o hospedeiro:
- os mecanismos patogênicos das micoses são em geral pouco compreendidos;
- não se identificam toxinas clássicas;
- os danos colaterais da resposta inflamatória parecem ser fortemente responsáveis pela morbidade nas micoses;
- nas infecções crônicas, pode ser observado um padrão inflamatório granulomatoso.




Considerações gerais:
- seres unicelulares eucariontes, intra ou extracelulares;
- de interesse infectológico, os flagelados, ciliados, sarcodíneos e esporozoários (classificação tradicional);
- adquirem forma cística em condições adversas (mecanismo de defesa que os permite sobreviver fora do hospedeiro);
- diversas espécies integram a microbiota normal.




Considerações gerais:
- transmissão em geral é fecal-oral ou por insetos;
- típicas em localidades com condições sanitárias precárias e difícil acesso à assistência médica;
- diagnóstico por microscopia do sangue ou fezes, histopatologia ou pesquisa de anticorpos ou DNA, conforme o caso;
- não há vacinas disponíveis.




Más condições sanitárias favorecem a transmissão fecal-oral e a disseminação de vetores, como o mosquito Anopheles spp. (malária) e o triatomíneo Triatoma infestans (doença de Chagas).



Principais agentes de interesse:
- Giardia lamblia, Leishmania spp., Trypanosoma cruzi e Trichomonas vaginalis (flagelados), Balantidium spp. (ciliados), Entamoeba histolytica e Acanthamoeba spp. (sarcodíneos), Cryptosporidium spp., Plasmodium spp. e Toxoplasma gondii (esporozoários; intracelulares obrigatórios).

Giardia lamblia (à esquerda), Trypanosoma cruzi (centro) e Leishmania spp. (à direita).



Principais agentes de interesse:



Trichomonas vaginalis, agente causador da tricomoníase, uma infecção sexualmente transmissível.



Particularidades da interação com o hospedeiro:
- podem infectar desde a pele e intestinos até o sangue (hemácias), coração e SNC, dentre outros órgãos/tecidos;
- os mecanismos patogênicos das protozooses variam muito conforme o agente e são parcialmente compreendidos;
- tipicamente resistentes aos mecanismos inatos de defesa.




Eritrócitos infectados pelo Plasmodium falciparum (à esquerda), cardiomiócitos infectados pelo Trypanosoma cruzi (centro) e o Toxoplasma gondii infectando o tecido encefálico (à direita).



Infecções protozoárias
Particularidades da interação com o hospedeiro:
- a E. histolytica produz poderosas enzimas digestivas que favorecem a invasão dos tecidos;
- protozoários intracelulares, como o Plasmodium spp., destroem as células dentro das quais se reproduzem;
- a Giardia lamblia fixa-se com ventosas ao epitélio intestinal, danificando-o e prejudicando-lhe a absortividade.




G. lamblia junto às vilosidades intestinais (detalhe da ventosa, à direita), vista por microscopia eletrônica de varredura colorizada.


Infecções metazoárias
Considerações gerais:
- seres eucariontes multicelulares, pertencentes ao reino animal;
- de interesse infectológico, os helmintos (vermes) trematódeos, cestódeos e nematódeos; - ciclo de vida complexo: inclui estágio larval e pode contar com mais de um hospedeiro intermediário; - tamanho adulto varia de 1 mm a vários metros, mas os ovos e larvas são microscópicos.




Infecções metazoárias
Considerações gerais:
- em geral adquiridos pela ingestão de ovos/larvas ou penetração cutânea (larvas); - humanos podem ser hospedeiros definitivos (vermes adultos) ou intermediários (p. ex., do Echinococcus granulosus e, eventualmente, da Taenia solium).




Infecções metazoárias
Considerações gerais:
- típicas em localidades com condições sanitárias precárias e difícil acesso à assistência médica;
- diagnóstico consiste na identificação morfológica (macro ou microscópica) do agente (em qualquer estágio); pesquisa de anticorpos ou DNA podem ser empregados conforme o caso.




Infecções metazoárias
Principais agentes de interesse:
- Schistosoma mansoni, Fasciola hepatica (trematódeos), Echinococcus granulosus, Hymenolepis nana, Taenia saginata e Taenia solium (cestódeos), Ancylostoma duodenale, Ascaris lumbricoides, Enterobius vermicularis, Strongyloides stercoralis, Trichuris trichiura e Wuchereria bancrofti (nematódeos).




Ovo, larva e formas adultas (macho e fêmea) do Schistosoma mansoni, um trematódeo.



Principais agentes de interesse:




Ovo e forma adulta Taenia solium, um cestódeo (à direita, detalhe do escólex).



Principais agentes de interesse:




Ovo e formas adultas do Ascari lumbricoides, um nematódeo.


Infecções metazoárias
Particularidades da interação com o hospedeiro:
- podem infectar desde a pele e intestinos até vasos sanguíneos ou linfáticos, pulmões e cérebro, dentre outros órgãos/tecidos;
- a doença pode estar relacionada aos estágios larval ou adulto, conforme o agente;
- a maioria das infecções intestinais torna-se patológica somente quando o número/tamanho dos agentes cresce em demasia.




Imagens endoscópicas de uma Taenia saginata no jejuno proximal (à esquerda) e de múltiplos
Ascaris lumbricoides obstruindo o piloro (à direita).


Particularidades da interação com o hospedeiro:



Humanos que ingerem ovos de T. solium figurarão como hospedeiros intermediários do agente, cujas larvas (cisticercos) tipicamente se alojam na musculatura estriada e SNC (neurocisticercose).



Infecções metazoárias
Particularidades da interação com o hospedeiro:
- os mecanismos patogênicos das helmintoses variam muito conforme o agente e são parcialmente compreendidos;
- os danos colaterais da resposta inflamatória parecem ser fortemente responsáveis pela morbidade nas helmintoses; - eosinofilia é uma manifestação cardinal e levanta suspeição (eosinófilos contêm grânulos tóxicos aos helmintos).




O achado de eosinofilia ao exame do sangue periférico é sugestivo de infecções helmínticas.


Princípios da prevenção às doenças infecciosas
Principais ações:
- saneamento (evitar contaminação do solo e água);
- controle de vetores;
- higiene;
- equipamentos de proteção;
- vacinação;
- isolamento e tratamento dos infectados.




A prevenção das doenças infecciosas depende de medidas individuais e coletivas.



Princípios da prevenção às doenças infecciosas
Principais ações:
- em virtude do seu impacto à saúde pública, muitas doenças infecciosas
são de notificação compulsória às autoridades sanitárias (HIV/AIDS, hepatites virais, raiva, sífilis, meningites, tuberculose, malária, febre amarela, dengue, cólera; lista completa em www.gov.br/saúde).




Infecções sexualmente transmissíveis podem ser prevenidas pelo uso de preservativos.


Princípios da prevenção às doenças infecciosas




O vírus da varíola, uma doença milenar, foi erradicado após décadas de campanhas mundiais de vacinação (os humanos eram seu único reservatório).



Pele
Topografia
Conjuntivas
Cavidade nasal e nasofaringe
Cavidade oral e orofaringe
Pulmões
Íleo distal e intestino grosso
Uretra distal
Vagina
Microbiota representativa ou de interesse médico
Aeróbios: Corynebacterium spp., Micrococcus spp., Staphylococcus aureus, Staphylococcus epidermidis; anaeróbios: Propionibacterium spp.; fungos: Candida spp., Malassezia spp.; vírus: Adenoviridae, Herpesviridae, Papillomaviridae, bacteriófagos.
Aeróbios: Corynebacterium spp., Micrococcus spp., Staphylococcus aureus, Staphylococcus epidermidis; anaeróbios: Propionibacterium spp.
Aeróbios: Moraxella spp., Neisseria meningitidis, Staphylococcus aureus, Staphylococcus epidermidis; anaeróbios:
Peptostreptococcus spp.; facultativos: Haemophilus influenzae, Streptococcus pneumoniae, Streptococcus viridans; vírus: Adenoviridae, Anelloviridae, Herpesviridae,Papillomaviridae, Redondoviridae, bacteriófagos.
Aeróbios: Moraxella spp., Neisseria spp.; anaeróbios: Bacteroides spp., Fusobacterium spp., Peptostreptococcus spp.; facultativos: Actinomyces spp., Streptococcus viridans; fungos: Aspergillus spp., Candida albicans, Cryptococcus spp.; vírus: Herpesviridae, Papillomaviridae, bacteriófagos.
Fungos: Aspergillus spp., Alternaria spp., Cladosporium spp.; vírus: Adenoviridae, Anelloviridae, Herpesviridae, Papillomaviridae, Redondoviridae, bacteriófagos.
Anaeróbios (99%): Bacteroides spp., Bifidobacterium spp., Clostridium spp., Eubacterium spp., Fusobacterium spp., Peptostreptococcus spp. Lactobacillus spp.; facultativos: Enterobacter spp., Enterococcus spp., E. coli, Klebsiella spp., Proteus spp., Pseudomonas spp.; fungos: Blastocystis spp., Candida spp.; protozoários: Enteromonas hominis, Pentatrichomonas hominis, Retortamonas intestinalis; vírus: Adenoviridae, Herpesviridae, Picornaviridae, bacteriófagos.
Aeróbios: Staphylococcus spp.; anaeróbios: Bacteroides spp.; facultativos: Enterococcus spp., Klebsiella spp., Lactobacillus spp., Proteus spp., Pseudomonas spp.; vírus: Herpesviridae, Papillomaviridae, bacteriófagos.
Aeróbios: Staphylococcus spp.; facultativos: Gardnerella vaginalis, Lactobacillus spp., Streptococcus spp.; fungos: Candida albicans; vírus: Herpesviridae, bacteriófagos.
Sangue, liquor, esperma Vírus (variáveis conforme o fluido): Anelloviridae, Herpesviridae,Papillomaviridae, Picornaviridae, bacteriófagos.
Principais representantes da microbiota indígena humana conforme a topografia.



Referências bibliográficas
Gerais:
1. Kumar V, Abbas A, Aster J. Robbins & Cotran: Pathologic basis of disease. 9th ed. Elsevier; 2016.
2. O'Dowd G, Bell S, Wright S. Wheather's Pathology: A text, atlas and review of histopathology. 9th ed. Elsevier; 2020.
3. Klatt E. Robbins & Cotran: Atlas of pathology. 3rd ed. Elsevier; 2015.
4. Buja L, Krueger G. Netter's Illustrated human pathology. 2nd ed. Elsevier; 2011.
5. Goldblum J, et al. Rosai & Ackerman's Surgical pathology. 11th ed. Elsevier; 2017.
Específicas:
1. Ryan KJ, Ahmad N, Alspaugh JA, et al. Sherri's & Ryan's Medical microbiology. 8th ed. McGraw-Hill; 2022.
2. Riedel S, Morse SA, Mietzner T, et al. Jawetz, Melnick & Adelberg's Medical microbiology. 28th ed. McGrawHill; 2019.
3. De la Maza LM, Pezzlo MT, Bittencourt CE, et al. Color atlas os medical microbiology. 3rd ed. American Society for Microbiology & Wiley; 2020.
4. Tortora GJ, Funke BR, Case CL. Microbiology: An introduction. 13th ed. Pearson; 2017.
5. Organização Pan-Americana de Saúde. Princípios de epidemiologia para o controle de enfermidades. Ministério da Saúde; 2010.
6. Ministério da Saúde. Guia de vigilância em saúde. 3ª ed. Ministério da Saúde; 2019.
7. Centers for Disease Control and Prevention (CDC). Principles of Epidemiology. 3rd ed. U.S. Department of Health and Human Services; 2012.




Referências bibliográficas
Complementares:
1. Sociedade Brasileira de Anatomia. Terminologia Anatômica. Manole; 2001.
2. Federative International Committee on Anatomical Terminology. Terminologia Histologica. LWW; 2008.
3. Ovalle WK, Nahirney PC. Netter: Bases da histologia. Elsevier; 2008.
4. Ross MH, Pawlina W. Histologia texto e atlas. 6ª ed. Guanabara Koogan; 2012.
5. Mills S. Histology for pathologists. 4th ed. LWW; 2012.
6. Alberts B, et al. Biologia molecular da célula. 6ª ed. Artmed; 2017.
7. Standring S. Gray's Anatomia: a base anatômica da prática clínica. 40ª ed. Elsevier; 2011.
8. Schunke M, Schulte E, Schumacher U. Prometheus: Atlas de anatomia. Guanabara Koogan; 2007.
9. Netter FH. Atlas de anatomia humana. 7ª ed. Elsevier; 2018.
10.Jansen JT, Netter FH. Netter's Clinical anatomy. 4nd ed. Elsevier; 2019.
11.Moore KL, Persaud PVN. Embriologia clínica. 10ª ed. Elsevier; 2016.
12.Boron W, Boulpaep E. Medical Physiology. 3rd ed. Elsevier; 2017.
13.Coico R, Sunshine G. Immunology. 7th ed. Wiley Blackwell; 2015.
14.Porto C, Porto A. Semiologia médica. 8ª ed. Guanabara Koogan; 2019.
15.Longo DL, Fauci AS, Kasper DL, et al. Medicina interna de Harrison. 18ª ed. Artmed; 2013.















"Não devemos nos sentir desencorajados pela dificuldade de interpretar a vida a partir das leis comuns da física".